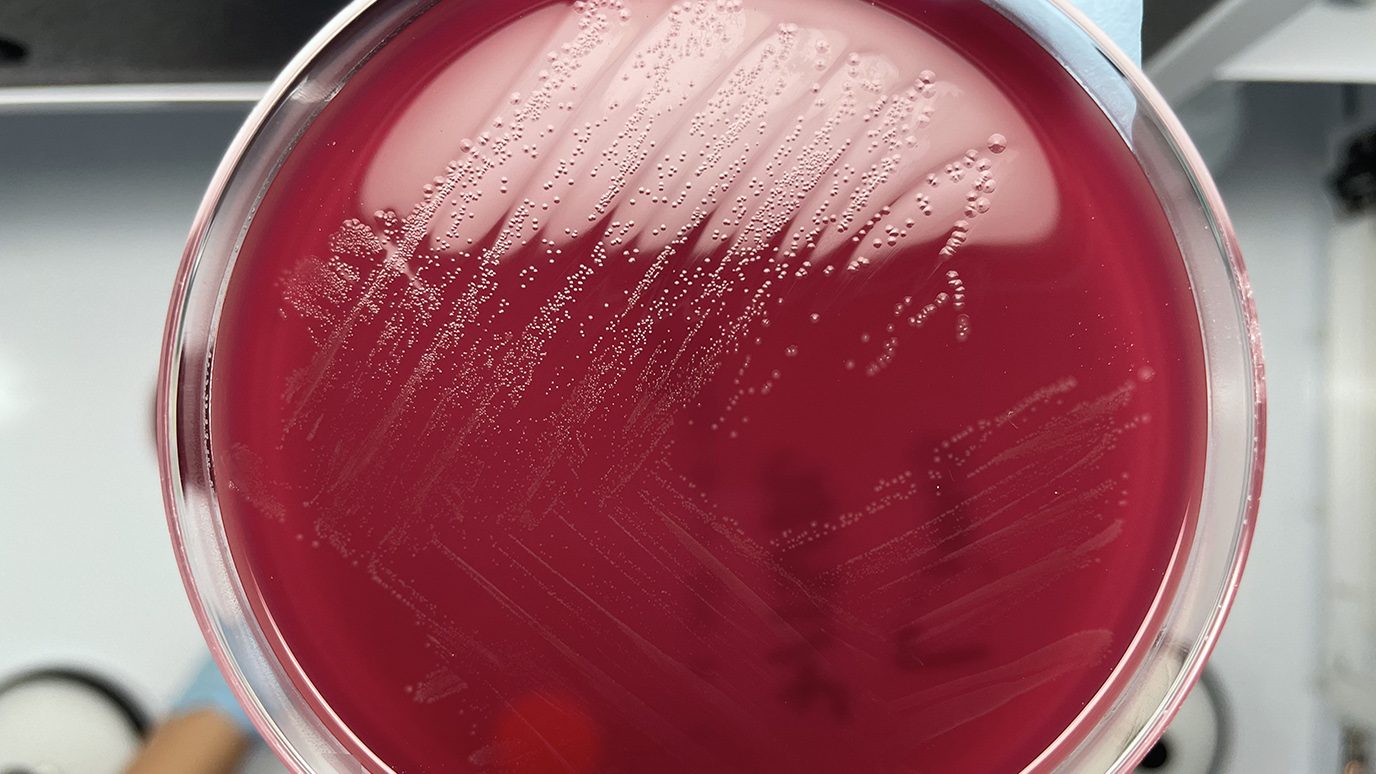

MD Anderson Research Highlights for October 25, 2023
The University of Texas MD Anderson Cancer Center’s Research Highlights showcases the latest breakthroughs in cancer care, research and prevention. These advances are made possible through seamless collaboration between MD Anderson’s world-leading clinicians and scientists, bringing discoveries from the lab to the clinic and back.
Recent developments at MD Anderson include positive results from a Phase I trial for patients with...

Lactate-producing bacteria inside tumors promote resistance to radiation therapy
Researchers at The University of Texas MD Anderson Cancer Center have discovered that lactate-producing intratumoral bacteria drives resistance...

MD Anderson Research Highlights: ESMO 2023 Special Edition
ABSTRACTS: LBA71, 1088MO, 95MO, LBA48, 1082O, 1085O, LBA34, 243MO
The University of Texas MD Anderson Cancer Center’s Research Highlights...
MD Anderson hosts 2023 Leading Edge of Cancer Research Symposium
The University of Texas MD Anderson Cancer Center will host its annual Leading Edge of Cancer Research Symposium Nov. 16-17, 2023, featuring presentations and discussions on genomics, immunity and inflammation, computational approaches for spatial biology, and emerging technologies that are driving the next wave of cancer breakthroughs.
The in-person symposium at MD Anderson will include keynote presentations from Paul Mischel,...


MD Anderson Research Highlights for October 4, 2023
The University of Texas MD Anderson Cancer Center’s Research Highlights showcases the latest breakthroughs in cancer care, research and prevention...